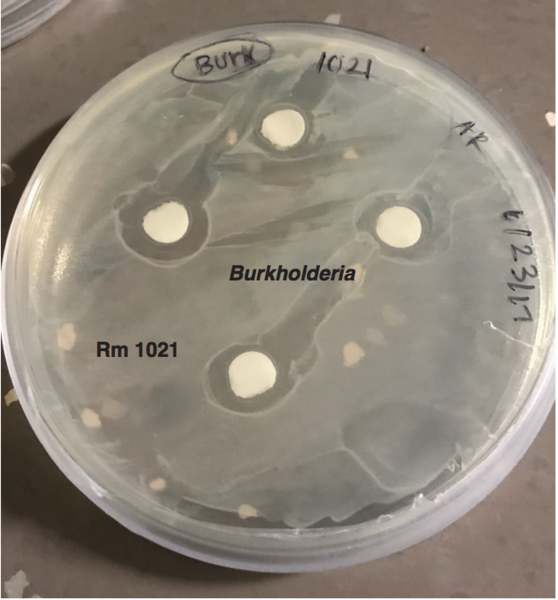
Investigating the Role of Biotic Factors in Host Responses to Rhizobia in the System Medicago truncatula

Here the authors used morphological characters and DNA barcoding to identify arthropods found within a residential house. With this method they identified their species and compared them against pests lists provided by the US government. They found that none of their identified species were considered to be pests providing evidence against the misconception that arthropods found at home are harmful to humans. They suggest that these methods could be used at larger scales to better understand and aid in mapping ecosystems.
Read More...